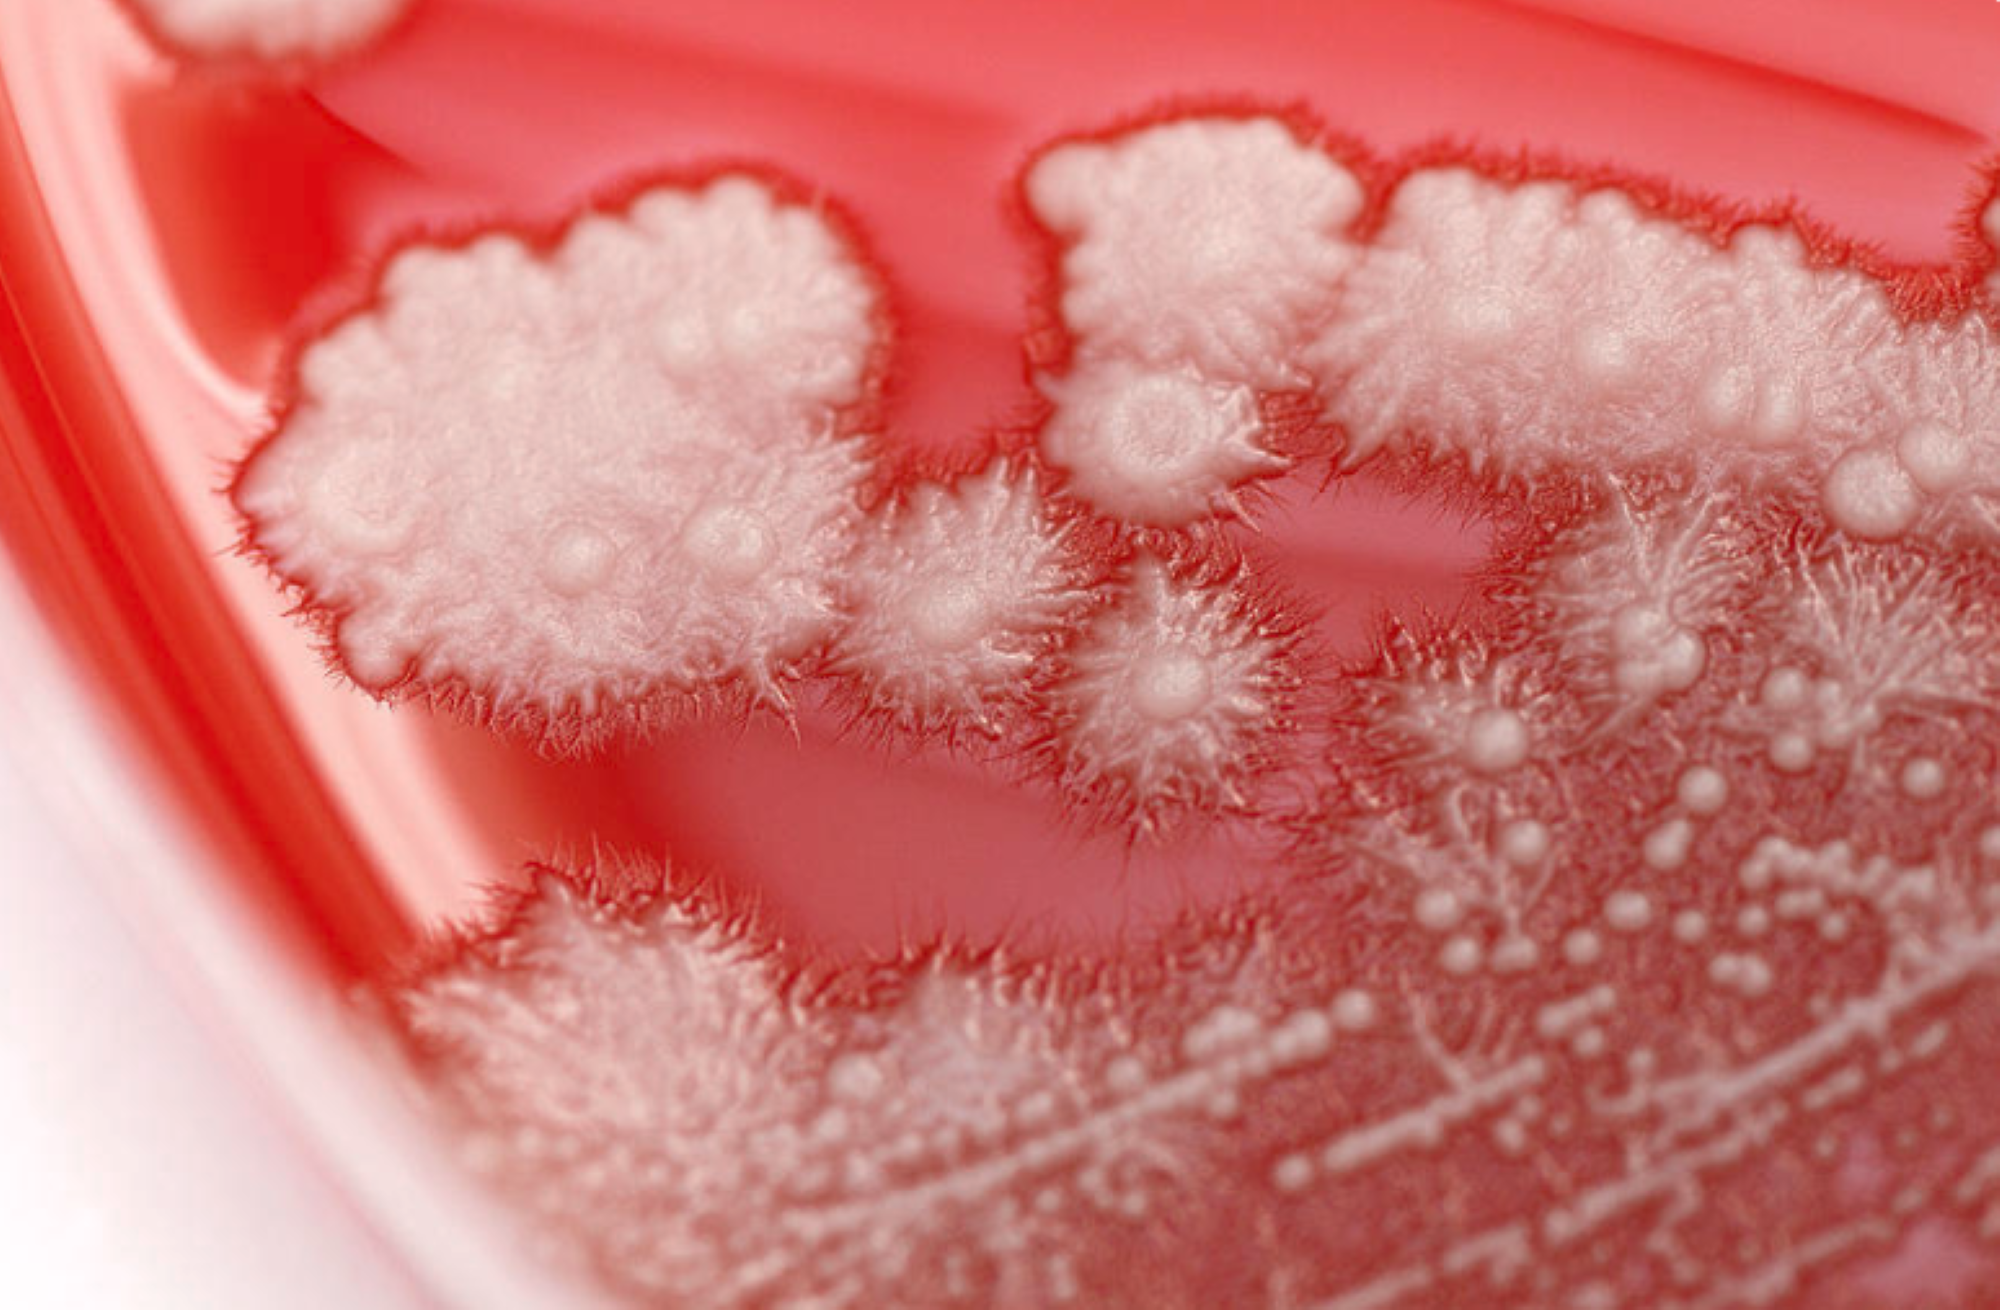

Кандидоз гомеопатия
Колечкин сборник задач по географии
Похороны маши прошли как в тумане
Двери капеллы
Магазин брестские гомель
Какие качества помогли вам в работе
Отображение девушки
Календарь садоводам алтайский край
Наречия без оглядки
Джиг на неве
Бутусов батрутдинов
Физиологические объемы легких
Системы воспитания а с макаренко
Симферополь севастопольская 22
Кандидоз гомеопатия 115 фотографий